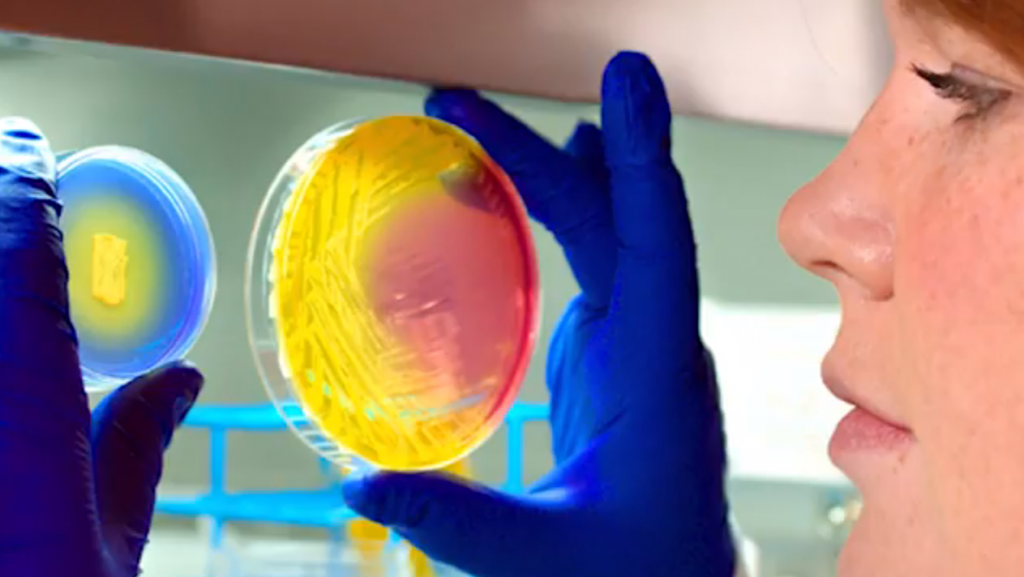

Drug-resistant bacteria are a hospital’s nightmare. Two out of every 100 people carry methicillin-resistant Staphylococcus aureus (MRSA), a bacteria that can’t be treated easily by antibiotics. When the bacteria multiplies, the infection can be deadly.
Engineer Liangfang Zhang at the University of California San Diego is developing a nanosponge that will soak up the nasty bacteria. The nanosponge is made from biocompatible, biodegradable polymer nanoparticles, and is designed to look like a red blood cell. Once in the bloodstream, the sponge attracts the toxins to it.
“A lot of the treatment we try to add something to the body to destroy the bugs or the cancer cells,” Zhang said. “This is doing the opposite.”
Zhang’s treatment has had a nearly 100 percent success rate in mice. And it doesn’t just work on bacteria. The sponges can soak up snake venom and other toxins too. Miles O’Brien has more on this story for the National Science Foundation’s series “Science Nation.”*
*For the record, the National Science Foundation is also an underwriter of the NewsHour.
ncG1vNJzZmivp6x7sa7SZ6arn1%2Bjsri%2Fx6isq2ejmLamusKeZqeZnqTAsbvNoJysZaOkrqx5w6usoGWimsCqv9Oapa1lmaOzpq%2FToqanqw%3D%3D